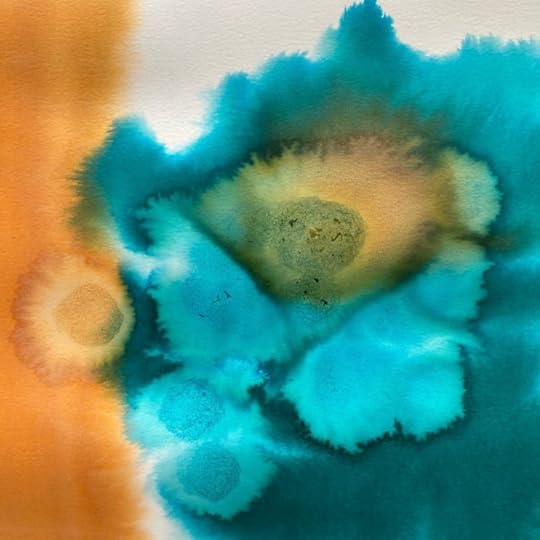

António Jorge Gonçalves's Blog, page 14
October 22, 2022
exposição DESENHAR DO ESCURO na Amadora
a exposição DESENHAR DO ESCURO na Galeria Artur Bual (Amadora) estará visitável até 6 novembro.
http://www.antoniojorgegoncalves.com/wp-content/uploads/2022/10/round_expo_amadora.mp4October 20, 2022
lançamento do livro VIGIA
no próximo sábado 22 outubro, entre as 16-19h, abro as portas do meu atelier na PENHA SCO (rua neves ferreira 10B, Lisboa) para apresentar o meu novo livro VIGIA e mostrar as aguarelas originais (que estão à venda). São duas novidades para mim: abrir as portas do atelier e vender originais.
quase a inaugurar
quinta 20 outubro às 18:30 inaugura a minha exposição DESENHAR DO ESCURO na Galeria Artur Bual integrada no Festival de Banda Desenhada da Amadora. Poderão ver grandes formatos dos meus desenhos a lápis branco (que estarão à venda), os cadernos originais e um pequeno filme documental sobre o processo. Fica até 6 de novembro. São todos bem vindos.
http://www.antoniojorgegoncalves.com/wp-content/uploads/2022/10/filme_autoretrato_expo_amadora.mp4
segunda feira
flor
O NASCIMENTO DA ARTE em Viseu
October 12, 2022
auto-edições
A auto-edição é um caminho novo para mim, cheio de entusiasmos e incertezas. Tudo começou há dois anos com a pequena tiragem caseira de “O AMOR É UM CADÁVER ESQUISITO” que recolhia uma seleção dos desenhos surrealistas conjuntos que eu e a Paula Delecave (e por vezes a Miranda) fazemos. No ano passado seguiu-se DESENHAR DO ESCURO que teve um acolhimento que superou bem as minhas expectativas. Agora chega VIGIA, e pelo andamento da carruagem também vai encontrar as mãos dos seus leitores. A auto-edição permite-me publicar livros que dificilmente encaixariam nas coleções editoriais de larga circulação; sem essa pressão comercial, que exige tiragens elevadas para cobrir os custos de todos os intervenientes (editora, distribuidor, livreiro), posso dedicar-me a escolher materias de qualidade e acabamentos que fazem destes livros objectos únicos. Também tem sido interessante envolver-me no processo completo, desde as idas frequentes à gráfica para acertar detalhes, passando pelas horas intermináveis a enviar e responder emails, até às viagens ao correio com malões cheios de caixas; limpar latrinas ou lavar roupa à mão nunca foram problema para mim, e fazer essas tarefas corriqueiras complementa bem as minhas horas de cabeça no ar. Acredito que estou a abrir um caminho particular, mais direto, até às pessoas que se interessam pelo meu trabalho. Uma economia local, de bairro global.
October 9, 2022
trailer VIGIA
aceito a partir de agora encomendas do meu novo livro VIGIA.
PROMOÇÃO LIMITADA
as primeiras 10 pessoas que encomendarem
2 exemplares do meu novo livro VIGIA,
terão como oferta (+ valor de portes)
esta serigrafia
edição CENTRO PORTUGUÊS DE SERIGRAFIA
50x70cm a 15 cores em papel Fabriano 290g,
tiragem de 150 (2019)
VIGIA, o meu novo livro
António Jorge Gonçalves's Blog
- António Jorge Gonçalves's profile
- 22 followers